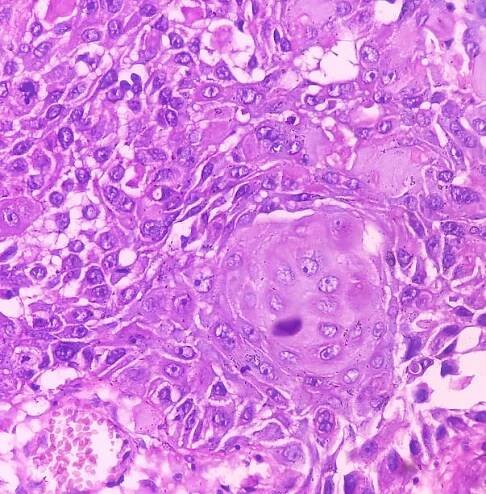

…carcinoma) je zhoubný nádor, který začíná v dlaždicových buňkách. Tyto tenké, ploché buňky svým vzhledem (pod mikroskopem) trochu připomínají rybí šupiny a nacházejí se v epitelové tkáni, která tvoří povrch kůže, výstelku dutých orgánů a výstelku dýchacích cest a trávicího traktu. Většina karcinomů děložního…
Skvamocelulární karcinom – Wikipedie
Skvamocelulární karcinom (latinsky Epithelioma spinocellulare) nebo také spinaliom je jedním z nejčastějších nádorů jak u lidí, tak u domácích zvířat.
Academy - Nádorová onemocnění: Spinocelulární karcinom
Spinocelulární karcinom je zhoubný nádor kůže, který se často zkráceně označuje jako spinaliom. Latinsky jde o spinalioma, anglickyz zase squamous cell…
Anální spinocelulární karcinom - Lohynská Radka - Megaknihy.cz
Skvamocelulární karcinom (latinsky Epithelioma spinocellulare) nebo také spinaliom je jedním z nejčastějších nádorů jak u lidí, tak u domácích zvířat. Jedná se o maligní nádor vytvořený z dlaždicovitých (spinocelulárních) buněk kůže. Tyto buňky jsou jednou z vrstev epitelové tkáně. Takové nádory se mohou vyskytovat také na sliznici. Wikipedie
odkazuje na služby nejen od Seznam.cz.
© 1996–2025 Seznam.cz, a.s.